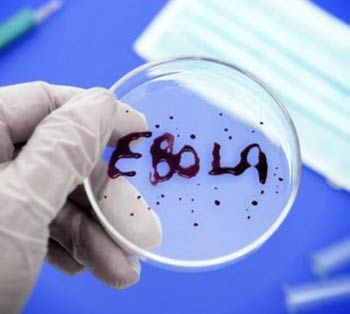
1-Ebola-sazog-2

საზოგადოება
ებოლას ვირუსის თავიდან ასაცილების მიზნით ჯანდაცვის სამინისტროში სპეციალური შტაბი შეიქმნა
საქართველო, 21 ოქტომბერი, საქინფორმი. შტაბი სამოქმედო გეგმის დეტალიზაციაზე მუშაობს და მას საქართველოს ჯანდაცვის მინისტრი დავით სერგეენკო ხელმძღვანელობს. გარდა ამისა, 4 ქვეყნიდან (ნიგერია, ლიბერია, გვინეა, სიერეა-ლეონე) საზღვარზე შემოსული ყველა ადამიანი გადის სათანადო შემოწმებას. 21 დღის განმავლობაში (მაქსიმალური ინკუბაციური პერიოდი) დაავადებათა კონტროლის ეროვნული ცენტრის წარმომადგენლები ახორცილებენ მათზე დაკვირვებას. ამ დროისთვის ამ 4 ქვეყნიდან სულ 86 ადამიანი შემოვიდა. ამჟამად დაკვირვების ქვეშ იმყოფება 13 ადამიანი.
სამინისტროს ცნობით, ვირუსის დროულად იდენტიფიცირებისთვის ტარდება ლექციების კურსი ექიმებისთვის, ჰემორაგული ცხელებების შესახებ, რომელთა რიცხვში ებოლას ვირუსიც შედის.
საქართველო, 21 ოქტომბერი, საქინფორმი. შტაბი სამოქმედო გეგმის დეტალიზაციაზე მუშაობს და მას საქართველოს ჯანდაცვის მინისტრი დავით სერგეენკო ხელმძღვანელობს. გარდა ამისა, 4 ქვეყნიდან (ნიგერია, ლიბერია, გვინეა, სიერეა-ლეონე) საზღვარზე შემოსული ყველა ადამიანი გადის სათანადო შემოწმებას. 21 დღის განმავლობაში (მაქსიმალური ინკუბაციური პერიოდი) დაავადებათა კონტროლის ეროვნული ცენტრის წარმომადგენლები ახორცილებენ მათზე დაკვირვებას. ამ დროისთვის ამ 4 ქვეყნიდან სულ 86 ადამიანი შემოვიდა. ამჟამად დაკვირვების ქვეშ იმყოფება 13 ადამიანი.
სამინისტროს ცნობით, ვირუსის დროულად იდენტიფიცირებისთვის ტარდება ლექციების კურსი ექიმებისთვის, ჰემორაგული ცხელებების შესახებ, რომელთა რიცხვში ებოლას ვირუსიც შედის. 
























